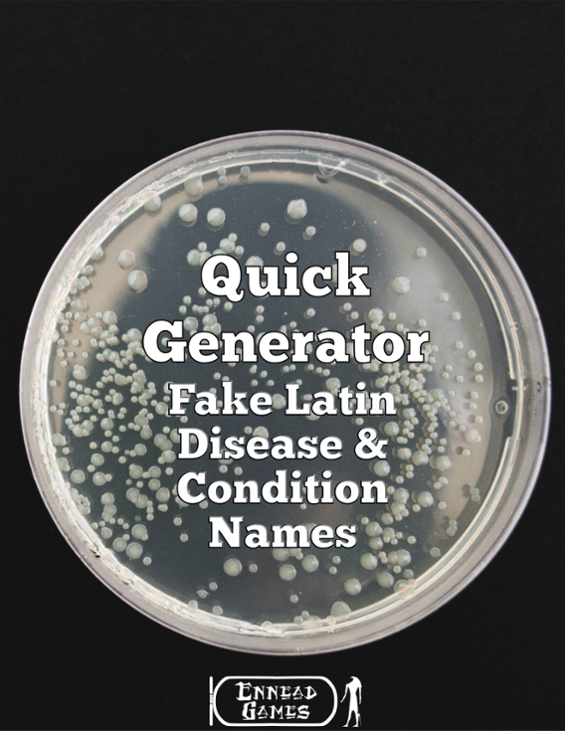
Games like QG - Fake Latin Disease & Condition Names

Games like QG - Fake Latin Disease & Condition Names
Looking for games like QG - Fake Latin Disease & Condition Names? Here are top action recommendations, selected from player-similarity data — start with Outside the Blocks, Lumnis or Champion of the Gods.
- 91%Game Brain Scoregraphics, musicoptimization, grinding91% User Score 105 reviews
Unleash Your CreativityStep into Outside the Blocks, the ultimate playground for builders and creators who want to express their artistic side in a relaxing, stress-free environment. Forget about objectives and pressure—immerse yourself in the pure joy of creation. Innovative Building ToolsCraft stunning, one-of-a-kind structures with our unique modular architectural block system. Whether you… If you enjoyed this game, see our list of games similar to Outside the Blocks.
View Game


Dive into an epic Action Adventure Souls-like journey mixing Climbing, Combat, and Exploration, to become the next Guardian of Lumnis, a once-peaceful land, now forgotten and shrouded in darkness since the arrival of an evil aura. To rid Lumnis of this blight, you will have to prove yourself worthy by finding the 11 keys of Ono scattered around Lumnis, and finally reach the place where Guardians … If you enjoyed this game, see our list of games similar to Lumnis.
View Game


- 86%Game Brain Scorestory, replayabilitymusic, gameplay86% User Score 143 reviews
In the battle to save your people, will you serve the gods or overthrow them? If you enjoyed this game, see our list of games similar to Champion of the Gods.
View Game


- 85%Game Brain Scorestory, music85% User Score 62 reviews
The young healer girl is accused of witchcraft after a strange disease outbreak in the town. Can the girl prove her innocence and find a real source of the epidemic? And who is this mysterious sorcerer who appeared at the same time with the disease? If you enjoyed this game, see our list of games similar to The Heiress of Sorcery.
View Game


- 34%Game Brain Scorestory, graphicsgameplay, music44% User Score 27 reviews
AETERNITAS! The RPG game where you get to be a student at an academy in a parallel world, where everyone can control the 4 elements. Brimming with humanity, new spells to learn, and stories beyond renown. If you enjoyed this game, see our list of games similar to AETERNITAS.
View Game


- 84%Game Brain Scorestory, musicgameplay91% User Score 46 reviewsCritic Score 77%3 reviews
"Welcome to Aquadine! My name is Ciel, and I'll be your tour guide for today!" A young gondolier works part-time to save money for his mother's hospital bills, but he has a secret. Follow Ciel as he tours people around the beautiful town of Aquadine, where his family and friends bond with him. If you enjoyed this game, see our list of games similar to Aquadine.
View Game


Try My Other Game! Waiting for A Case of Missing Identity to release? Try my other game while you wait - Veins Like Tapeworms! With 6 endings, 100,000 words, 8 chapters and over 250 illustrations, the miserable fate of Demian Zhao is sure to unnerve you! About the GameFrom the creator of Veins Like Tapeworms, A Case of Missing Identity is a point-and-click horror/tragedy visual novel, about h… If you enjoyed this game, see our list of games similar to A Case of Missing Identity.
View Game


- View Game52%Game Brain Score52% User Score 3 reviews
Jumpman - BASIC 10Liner Contest 2023 ==================================== Author: Eric Carr Language: FastBasic 4.6 Platform: Atari 8-bit (tested on 130XE NTSC) Category: EXTREM-256 Video: Requirements: System: Atari 8-bit w/ 48KB+ memory (800, xe, etc) w/ Joystick Emulator: Atari800MacX (on Mac) or Altirra (Windows) *** NTSC / PAL NOTE: This game was designed on NTSC. All SOURCE/LISTING/S… If you enjoyed this game, see our list of games similar to Jumpman (Atari 8-Bit) by Eric Carr.
- 54%Game Brain Scoremusic, graphicsoptimization, gameplay86% User Score 14 reviews
Fold & Fly is a relaxing yet fast-paced flying game where you guide a paper plane through whimsical worlds. Collect stars to raise your score, catch origami dragonflies to open portals, explore infinite, procedurally generated dreamscapes and use seeds to create new maps and save your favorites. If you enjoyed this game, see our list of games similar to Fold & Fly.
View Game


- 68%Game Brain Scorestory, musicgraphics, character development100% User Score 19 reviews
Immerse yourself in the world of intrigue and art scandals with Arts&Hearts Academy. You'll shiver but beg for more! A girl from a provincial architecture college dreams of winning a prestigious competition. But everything seems to be against her: hostile competitors, disagreements inside her team, and secrets hidden within the walls of the Architecture Academy. She must uncover the long-forgo… If you enjoyed this game, see our list of games similar to Arts & Hearts Academy.
View Game